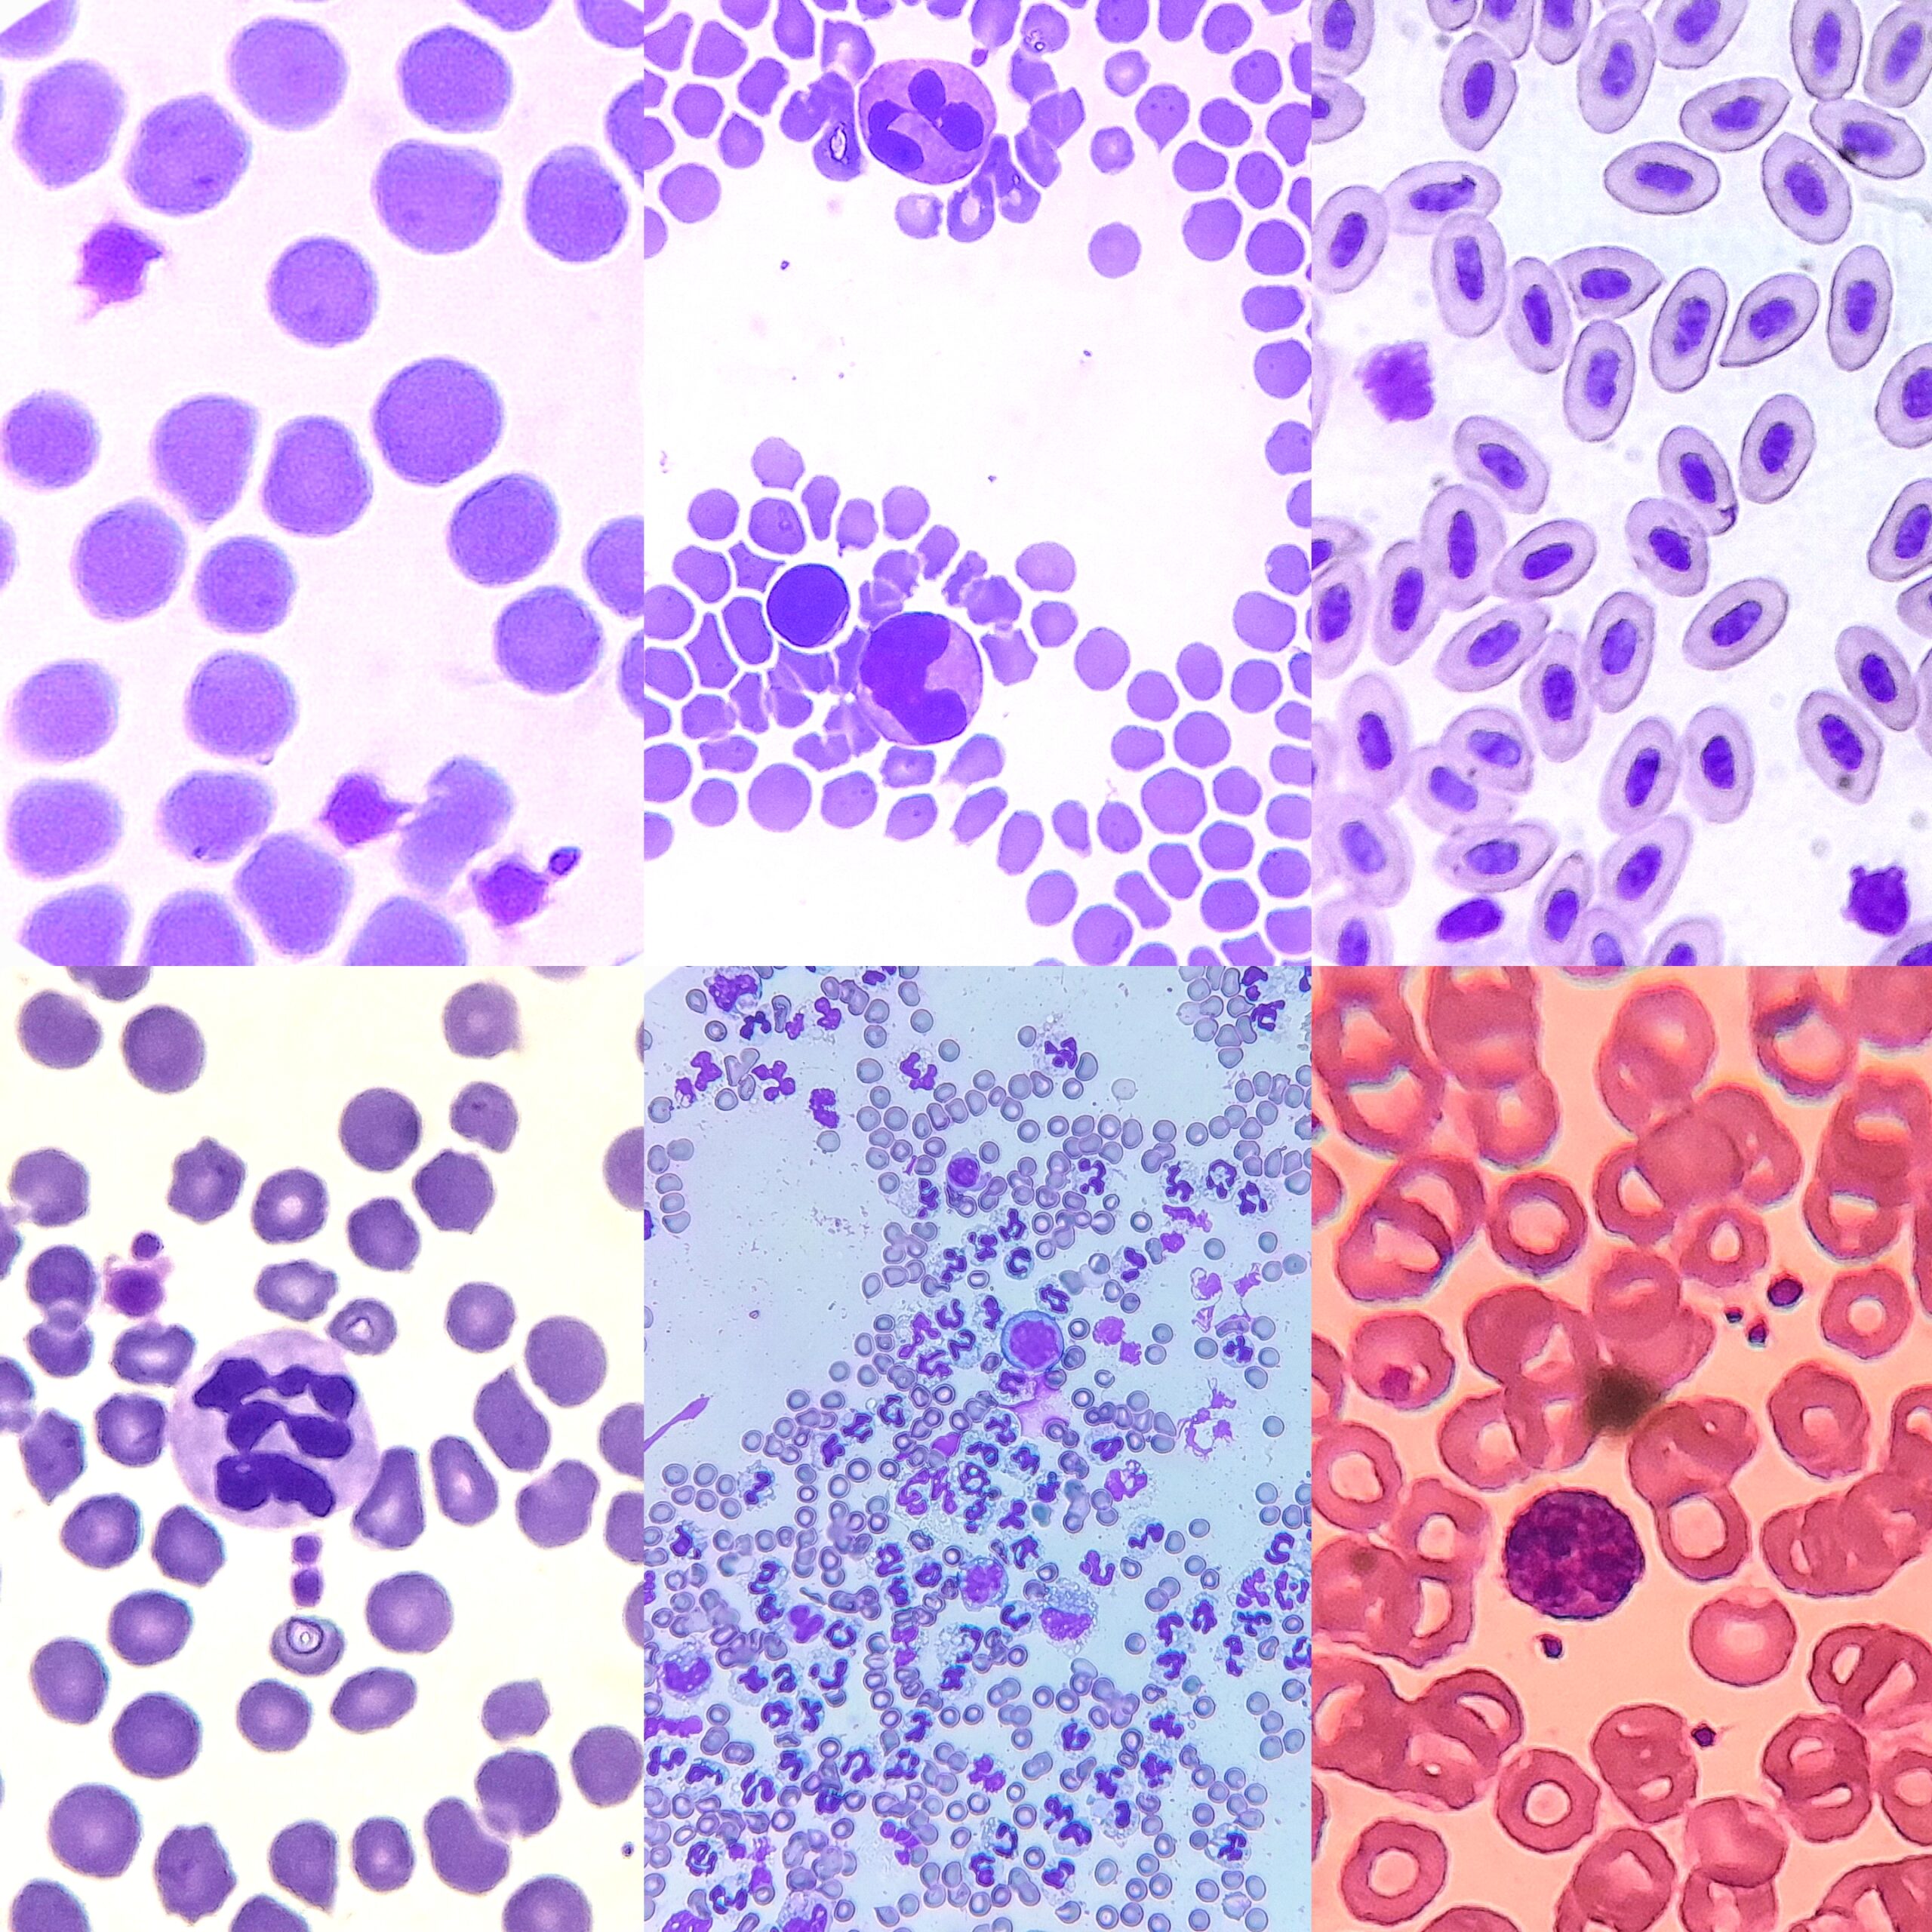

Atlas de Microscopia
O objetivo deste Atlas é servir como um acervo completo do laminário disponível no laboratório da instituição, incluindo também materiais extras obtidos durante estágios, adicionados para ampliar o conteúdo. Os materiais foram organizados de acordo com os principais tópicos trabalhados em cada disciplina, facilitando a consulta, o estudo, a compreensão das estruturas celulares, teciduais e morfológicas, e estimulando a curiosidade dos acadêmicos.
Histologia

Tecidos
O acervo dos tecidos apresenta tópicos abordados na matéria de histologia básica

Sistemas
O acervo dos sistemas apresenta tópicos abordados na matéria de histologia dos sistemas e histologia médica
Hematologia
Sangue
Neste tópico foi apresentado células que compõem o sistema cardiovascular, o acervo não é presente na instituição.

Profª ME. Deusângela Graçano Araújo
Coordenadora do curso de Biomedicina, professora da disciplina de Histologia Básica e Histologia dos Sistemas.

Lívia de Souza Moura
Acadêmica do Curso de Medicina Veterinária na instituição, editora do Atlas.